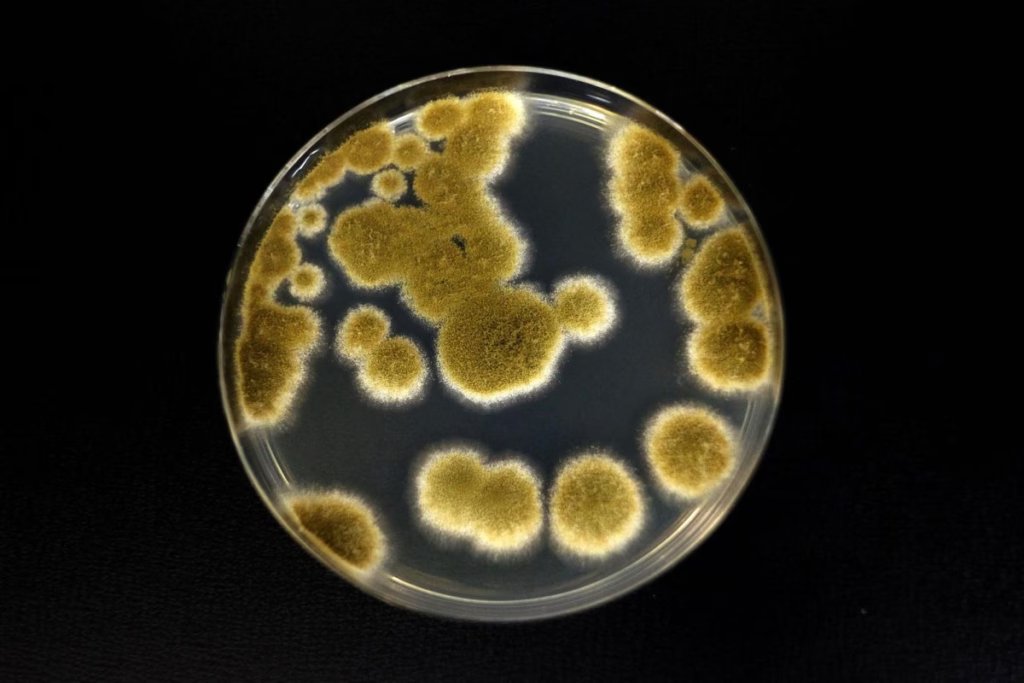

Деякі мікроорганізми на Землі виявилися значно стійкішими, ніж вважалося раніше. Нове дослідження показує, що певні види грибів можуть витримати умови, наближені до польоту з Землі на Марс, що ставить нові питання про межі виживання життя у космосі.
Робота, опублікована в журналі Applied and Environmental Microbiology, зосередилася на грибкових мікроорганізмах, знайдених у надчистих приміщеннях NASA — спеціальних лабораторіях, де збирають і тестують космічні апарати. Попри суворий контроль і стерильність, деякі мікроби все ж виживають.
Гриби, які витримують космічний “стрес”
У центрі дослідження опинився гриб Aspergillus calidoustus. Його спори витримали умови, які імітували ключові етапи місії на Марс: сильне ультрафіолетове та іонізуюче випромінювання, наднизький тиск, холод і контакт із марсіанським ґрунтом.
Науковці також використали 27 грибкових штамів, зібраних під час підготовки місії Mars 2020 mission, яка доставила марсохід Perseverance на Червону планету. Додатково були протестовані ще кілька особливо стійких мікроорганізмів.
Чому це важливо для космічних місій
За словами керівника дослідження, мікробіолога Kasthuri Venkateswaran, результати не означають, що Марс уже забруднений земним життям або що це неминуче станеться. Проте вони допомагають точніше оцінити ризики.
Мікроорганізми виявилися здатними витримувати не один, а одразу кілька екстремальних факторів. Найбільш критичним для них виявилося поєднання сильного холоду та високої радіації — саме цей тандем знищував спори.
Чому навіть “чисті” лабораторії не стерильні
NASA використовує спеціальні cleanroom-приміщення, де повітря постійно фільтрується, а поверхні регулярно стерилізуються. Але навіть там деякі мікроби з часом пристосовуються до суворих умов — низької вологості, нестачі поживних речовин і дезінфекції. Це робить їх особливо важливими для програм планетарного захисту, які мають запобігти перенесенню земного життя на інші планети.
Потенційна загроза для майбутніх місій
Дослідження показало, що деякі грибкові спори можуть пережити не лише підготовку космічного апарата, а й тривалу подорож у космосі, а також потенційно залишатися життєздатними на поверхні Марса.
Це означає, що навіть ретельна стерилізація космічних апаратів може бути недостатньою, якщо мікроорганізми мають природні механізми виживання в екстремальних умовах.
Що це змінює для науки
Результати допомагають уточнити стратегії планетарного захисту, які розробляє NASA. Вони також впливають на оцінку ризиків майбутніх місій, де важливо не лише знайти сліди позаземного життя, а й не занести туди земне.
Погляд у майбутнє
Хоча дослідження не доводить, що життя легко може поширюватися між планетами, воно показує: деякі форми життя значно витриваліші, ніж ми уявляли. І це означає, що питання “чи можемо ми випадково занести життя на Марс” стає дедалі більш науковим, а не теоретичним.